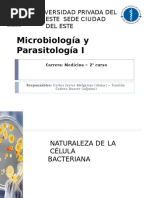

Actualizado el mircoles, 15 febrero 2006
NDICE:
1 FLAGELOS 1.1 1.2 1.3 INTRODUCCIN: LA MOVILIDAD EN LAS BACTERIAS ASPECTOS MORFOLGICOS COMPOSICIN QUMICA Y ESTRUCTURA 1.3.1 FILAMENTO 1.3.2 CODO O GANCHO 1.3.3 CORPSCULO BASAL 1.4 1.5 ENSAMBLAJE DEL FLAGELO MOVIMIENTO FLAGELAR 1.5.1 DESCRIPCION DEL MOVIMIENTO DE UNA BACTERIA PERITRICA 1.5.2 MECANISMO DEL MOVIMIENTO ALEATORIO (EN AUSENCIA DE ESTMULO) 1.5.2.1 1.5.2.2 1.5.2.3 EL MOTOR ES ROTATORIO Y GIRA EN AMBOS SENTIDOS COMPONENTES DEL MOTOR Y DEL CONMUTADOR ASPECTOS ENERGTICOS
1.5.3 LAS TAXIAS 1.5.3.1 1.5.3.2 1.5.3.3 DEFINICIONES TIPOS DE TAXIAS ESTUDIO DE LA QUIMIOTAXIA Y DE LA ADAPTACIN
1.5.3.3.1 ESTMULOS DEL SISTEMA DE RECEPCIN, TRANSDUCCIN DE SEAL Y ADAPTACIN 1.5.3.3.2 EL CICLO DE EXCITACIN-ADAPTACIN 2 3 FLAGELOS PERIPLSMICOS FIMBRIAS O PELOS (= PILI) 3.1 3.2 4 5 FIMBRIAS ADHESIVAS PELOS SEXUALES DE BACTERIAS GRAM-NEGATIVAS
PROSTECAS TALLOS O PEDNCULOS
ENLACES DIAPOSITIVAS
1 FLAGELOS
1.1 INTRODUCCIN: LA MOVILIDAD EN LAS BACTERIAS
Los procariotas capaces de moverse lo hacen por alguno de estos sistemas: Por flagelos provistos de un motor rotatorio
converted by Web2PDFConvert.com
�Por pelos de tipo IV, que dan lugar a dos tipos de desplazamiento: Por sacudidas o contracciones en ciertas especies (de los gneros Neisseria y Pseudomonas) Movilidad social por deslizamiento sobre superficies slidas en mixobacterias Por secrecin de sustancias mucosas a travs de toberas (conjuntos de poros especiales) en la superficie celular: lo que da origen a deslizamiento en ciertas cianobacterias y en mixobacterias, a modo de patinaje de la clula sobre el moco depositado sobre la superficie. Por un mecanismo de trinquete, responsable del deslizamiento en especies del grupo Cytophaga-Flavobacterium. En este caso existen un doble juego de protenas, uno de membrana citoplsmica y otro de membrana externa. Ambos juegos estn engarzados entre s probablemente a nivel del peptidoglucano. Las protenas de membrana citoplsmica se desplazan, y a su vez provocan movimiento en las de membrana externa. Todo ello se asemeja a una correa sin fin o cadena de un tanque, que al moverse en un sentido sobre una superficie, impulsan a la clula en el sentido opuesto. El mejor estudiado de todos esos sistemas es de los flagelos. Los flagelos eubacterianos tpicos son largos apndices filamentosos extracelulares, helicoidales, responsables del desplazamiento en medios lquidos de la mayor parte de las bacterias mviles. Aunque empleamos la misma palabra para designar a los orgnulos locomotores de procariotas y eucariotas, ambos son totalmente diferentes, tanto en estructura como en mecanismo de funcionamiento: El filamento del flagelo bacteriano, que constituye su porcin externa ms visible, consta generalmente de un solo tipo de protena, y en l no se realiza ningn trabajo quimiomecnico. El mecanismo del flagelo bacteriano es rotatorio, con un motor reversible (funciona en los dos sentidos de giro). La energa que propulsa a este motor no es ATP ni ninguna otra molcula con enlaces energticos, sino que deriva directamente del gradiente de protones (fuerza protn-motriz).
1.2 ASPECTOS MORFOLGICOS
En preparaciones en fresco a microscopa ptica normal no se pueden detectar los flagelos individuales, debido a su extrema delgadez (estn ligeramente por debajo del lmite resolutivo del microscopio). El microscopio de contraste de fases logra visualizar los penachos densos de flagelos de ciertas bacterias. En cambio, la microscopa ptica de alta intensidad en campo oscuro, as como la microscopa fluorescente s logra discernir los flagelos. Pueden estudiarse fcilmente mediante impregnacin argntica en preparaciones previamente fijadas por procedimientos suaves que no destruyan la estructura (alcohol-ter) y con mordientes que la engruesan artificialmente: cido tnico, sales de Al y Cr. (remitimos al alumno a la correspondiente prctica). Los flagelos se observan como filamentos helicoidales largos y finos. La longitud es variable (no est determinada de modo fijo): de 5 a 10 mm, pero su anchura o dimetro es constante y uniforme para cada especie: en Escherichia coli es de 20 nm. El carcter helicoidal del filamento es propio e intrnseco: para cada especie los parmetros de la hlice (longitud de onda y amplitud) son fijos y caractersticos. Existe una serie de especies Gram-negativas (Vibrio, Photobacterium, Bdellovibrio) que poseen flagelos muy engrosados, debido a que estn envueltos en una vaina que presenta continuidad con la membrana externa.
El patrn de flagelacin (es decir, el nmero y localizacin de los flagelos) vara entre especies, y reviste inters en la determinacin
taxonmica: un solo flagelo: bacterias monotricas. Normalmente la insercin del flagelo (en bacterias bacilares) es polar o subpolar. dos o ms flagelos formando un penacho, normalmente en un polo: lofotricas. (por ejemplo, en Spirillum volutans hay ms de 80 flagelos en el penacho). dos penachos de flagelos, uno en cada polo: bacterias anfitricas. flagelos repartidos por toda la superficie: bacterias peritricas. (Por ejemplo, Escherichia coli posee 10 flagelos, mientras que Proteus mirabilis posee cientos, dando aspecto muy denso a la disposicin de stos). Ciertas bacterias presentan flagelos de insercin lateral, bien en penachos densos (Selenomonas), bien diseminados (Pectinatus). Existe una serie de especies Gram-negativas (Vibrio, Photobacterium, Bdellovibrio) que poseen flagelos muy engrosados, debido a que estn envueltos en una vaina que presenta continuidad con la membrana externa
1.2 COMPOSICIN QUMICA Y ESTRUCTURA
El flagelo eubacteriano es una de las estructuras procariticas ms complejas, formada por ms de 20 tipos de protenas estructurales. Ya a microscopa electrnica se pueden distinguir tres partes o subestructuras:
filamento helicoidal largo; est conectado a un corto segmento curvado denominado... codo o gancho, que a su vez est unido al... corpsculo basal. Este corpsculo basal est inmerso en las envueltas (membrana citoplsmica y pared), y consta esencialmente
de un cilindro que ensarta 1 o 2 parejas de anillos. En los ltimos aos se ha visto que, relacionado con este corpsculo existen ms subestructuras. En conjunto, este corpsculo ampliado que ahora conocemos tiene varias funciones: anclar el flagelo a las envueltas suministrar el mecanismo del movimiento (un motor rotatorio que puede girar en ambos sentidos) albergar la maquinaria de exportacin de subunidades de protenas para su ensamblaje en la estructura flagelar acabada
converted by Web2PDFConvert.com
�Estructura de un flagelo de una bacteria Gram-negativa
1.3.1 FILAMENTO
El filamento es una estructura cilndrica fina, hueca y rgida, con aspecto helicoidal. Est constituido por el arrollamiento de miles de subunidades idnticas de una protena llamada flagelina. La flagelina es una protena globular relativamente elongada, con pesos moleculares variados, segn las especies (desde unos 15 kDa en algunos Bacillus hasta unos 62 kDa en algunas enterobacterias). Las subunidades de flagelina se disponen formando una matriz cilndrica, en la que se distinguen 11 hileras cuasi-axiales (casi verticales) de subunidades; las hileras cuasi-axiales se denominan fibrillas. El cilindro est hueco (deja un canal en su interior de unos 3 nm). El filamento es notablemente rgido, de modo que durante el movimiento activo slo se producen pequeas deformaciones, pero sin afectar a los parmetros de la hlice. En el extremo distal del filamento existe un capuchn formado por un pentmero de una protena distinta (HAP2). Entre el filamento y el codo existen dos discos estrechos con dos tipos de protenas (HAP3 y HAP1). Son estructuras adaptadoras que permiten la correcta interaccin entre filamento y codo. El filamento tiene un papel pasivo, actuando de manera anloga a la hlice de un barco. El movimiento de rotacin del motor (situado, como veremos, en el corpsculo basal) se comunica (a travs del codo) al filamento helicoidal rgido, lo que permite el avance de la bacteria. Tanto la flagelina nativa aislada como los filamentos intactos son buenos antgenos, constituyendo el denominado antgeno H
flagelar, especfico para cada especie e incluso para cada estirpe o raza.
1.3.2 CODO O GANCHO
Es una estructura curvada, acodada, de 55 nm de longitud, y 22 nm de dimetro, que conecta el filamento al corpsculo basal. Consta de unas 120 unidades de una protena elongada, distinta de la flagelina (42 kDa), dispuestas igualmente en una matriz cilndrica de 11 fibrillas. Parece ser que el codo acta a modo de juntura universal o flexible entre el filamento y el corpsculo basal. Entre el codo y el filamento existen dos discos de protenas accesorias del codo (HAP1 y HAP3). Cada uno de los discos consiste en dos giros de hlice, e intervienen en el control del ensamblaje del flagelo. Son estructuras adaptadoras que permiten la correcta interaccin entre filamento y codo.
1.3.3 CORPSCULO BASAL
Entendido el corpsculo basal en su sentido actual (ms amplio de lo que sabamos hace unos aos), es una notable estructura que, inmersa en la membrana citoplsmica y en la pared celular, posee varias funciones:
ancla el flagelo a la clula est relacionada con la funcin del motor rotatorio y del conmutador (cambio del sentido de giro) alberga el aparato para la secrecin y correcto ensamblaje de la mayor parte del flagelo
En Gram-negativas, consta de dos pares de anillos coaxiales atravesados por un cilindro central hueco, junto con otra serie de subestructuras anejas a todo lo anterior: Los dos anillos exteriores se denominan L y P, y estn relacionados respectivamente con la membrana externa y con el peptidoglucano. (A veces estos dos anillos estn conectados por una pared cilndrica que enmascara la porcin del cilindro central).
converted by Web2PDFConvert.com
�Los dos anillos interiores se denominan S y M: el S est en el espacio periplsmico, inmediatamente por encima de la membrana citoplsmica, y el M est inmerso plenamente en dicha membrana. Como ambos anillos estn muy juntos, a veces se alude a ellos como anillo MS. Ya hacia el lado citoplsmico de la membrana, por debajo del anillo M (y en contacto con l) existe un quinto anillo, llamado anillo C, en el que existen tres protenas. Una de ellas, (FliG) parece ser el elemento central del rotor, mientras que las tres (FliG, FliM y FliN) estn implicadas en la conmutacin del sentido del giro del motor: permiten que el motor pueda girar en sentido de las agujas del reloj y en el sentido contrario al de las agujas del reloj. Rodeando al corpsculo basal, a modo de empalizada cilndrica, existen subunidades de dos protenas integrales de membrana: MotA y MotB . Su papel parece ser doble: Constituyen el estator del motor. Se sabe que MotB se proyecta hacia el espacio periplsmico, y probablemente establece contactos con el peptidoglucano. Por otro lado forman una especie de canal por donde pueden entrar los protones al citoplasma, lo que constituye la base del mecanismo que surte de energa al motor. En el hueco interior formado por los anillos MS y C se aloja una serie de protenas implicadas en la secrecin de los monmeros de componentes del flagelo. Con todo ello, la hiptesis que se maneja hoy es que, con el carburante de protones, el rotor gira respecto del estator. Este giro se comunica al cilindro central, que a su vez debe de estar bien engarzado con al menos alguno de los otros cuatro anillos. El giro se transmite al codo y, de ste al filamento. Como el filamento es una hlice rgida, al girar hace avanzar a la bacteria en el medio acuoso. En Gram-positivas la estructura del corpsculo basal es ms sencilla: cilindro central y una sola pareja de anillos (el M y el S). Probablemente el anillo S est conectado con el peptidoglucano (sera anlogo en realidad al anillo P de las Gram-negativas).
1.4 ENSAMBLAJE DEL FLAGELO
En la construccin del flagelo bacteriano intervienen unas 50 protenas, entre protenas estructurales que formarn parte de la estructura definitiva (unas 20), y protenas accesorias que slo sirven durante este ensamblaje (unas 30). Debido a esta complejidad, y a que, adems, diversas partes del flagelo deben de interaccionar con las envueltas bacterianas (membrana, pared), no es de extraar que este ensamblaje est bien ajustado ni que la sntesis de las diversas piezas est sometida a un estricto control gentico. El orden de ensamblaje es en su mayor parte lineal y secuencial: tiene lugar desde las subestructuras ms proximales hasta las ms distales. Los componentes integrales de membrana (excluyendo a las protenas Mot), el doble anillo MS y el anillo C emplean la habitual ruta Sec (procesamiento de pre-protenas con escisin del pptido lder). Pero la mayor parte de las protenas cuyo destino est ms all de la membrana citoplsmica usan una ruta especial, que es una variante del denominado sistema III de exportacin. Como dijimos, el aparato para esa exportacin se alberga en el hueco de los anillos MS. Este aparato va exportando ordenadamente las subunidades de las distintas subestructuras, las cuales viajan en fila india a travs del canal interior continuo (que a su vez se va construyendo) del cilindro codo filamento. Las subunidades se van aadiendo en el correspondiente extremo distal de la subestructura en formacin, y evitan su escape al medio merced a unas protenas de capuchn en dichos extremos distales. Por ejemplo, el filamento en construccin siempre dispone en su extremo distal de un capuchn del pentmero de la protena HAP2. Dicho capuchn es plano hacia el exterior, pero posee cinco patas hacia abajo, que forman una especie de cavidad relativamente amplia. Cuando por el hueco interior viaja una nueva unidad de flagelina (an sin terminar de plegar), al llegar a la cavidad, hay un cambio de conformacin en las patas de HAP2 que a su vez favorece el plegamiento adecuado de la flagelina y su insercin en el lugar correcto. Cada vez que llega una subunidad de flagelina, el pentmero sufre el cambio conformacional, y para acomodar la nueva subunidad se desplaza rotacionalmente, es decir, en el ensamblaje, el pentmero de HAP2 est girando continuamente.
1.5 MOVIMIENTO FLAGELAR
En este apartado nos vamos a plantear dos objetivos de estudio principales: descripcin del movimiento por flagelos (apartados 1.5.1) mecanismo del movimiento en ausencia de estmulos (1.5.2) cmo se ve modificado el mecanismo flagelar bsico ante la llegada de estmulos ambientales captados en la superficies celular (1.5.3).
1.5.1 DESCRIPCION DEL MOVIMIENTO DE UNA BACTERIA PERITRICA
Vamos a estudiar en primer lugar cmo se produce el movimiento en bacterias peritricas como Escherichia coli o Salmonella
tiphymurium.
1. En ausencia de estmulos , en un medio ambiente uniforme, se puede observar un movimiento tridimensional aleatorio, formado por periodos de unos pocos segundos de natacin en linea recta o ligeramente curvada (carreras o corridas ), interrumpidos por breves episodios (dcimas de segundo) de un movimiento angular catico de la bacteria (viraje o cabeceo ), tras de lo cual la clula entra en una nueva fase de natacin en lnea aunque con una nueva direccin. 2. En un gradiente espacial de un estmulo ambiental, la bacteria responde modificando el anterior patrn. Se alteran las
converted by Web2PDFConvert.com
�probabilidades relativas de carreras y de virajes, de modo que la bacteria prolonga estadsticamente los periodos de natacin hacia la direccin favorable (es decir, acercndose hacia un estmulo positivo y alejndose de uno negativo), y disminuye la frecuencia de cabeceo. De esta manera se obtiene una locomocin aleatoria pero estadsticamente sesgada, que propicia el avance neto en la direccin favorable. Este movimiento se denomina taxia. 3. El comportamiento txico dura un tiempo limitado, que oscila de segundos a minutos, dependiendo de la naturaleza e intensidad del gradiente. Tras la fase de excitacin inicial y de taxia, la bacteria se va adaptando al estmulo , de modo que regresa finalmente al patrn aleatorio de movimiento, sin avance neto en ninguna direccin. As pues, en las prximas pginas veremos la base de estos fenmenos: existencia de un rotor flagelar de tipo rotacional, que es reversible. Veremos que la bacteria tiene mecanismos para detectar un gradiente espacial de un estmulo, y comprobaremos que este mecanismo acta como si la bacteria estuviera detectando de hecho un gradiente temporal. Conectado con el sistema de deteccin de estmulos, hay un sistema que hace que se vuelva al patrn aleatorio ante la persistencia del estmulo (mecanismo de adaptacin).
1.5.2 MECANISMO DEL MOVIMIENTO ALEATORIO (EN AUSENCIA DE ESTMULO)
Vamos a resumir lo que veremos con ms detalle a continuacin: El motor es rotatorio y tiene dos estados: giro en sentido antihorario, es decir contrario a las agujas del reloj (CAR), y sentido horario, igual al de las agujas del reloj (AR) Componentes y funcionamiento del motor y del conmutador y su relacin con la movilidad por carreras y con las volteretas Aspectos energticos del motor: el carburante del motor es la disipacin de protones a travs de cierta parte del corpsculo basal.
1.5.2.1 EL MOTOR ES ROTATORIO Y GIRA EN AMBOS SENTIDOS
Desde hace varios aos, por experimentos en los que las bacterias quedaban unidas a cubreobjetos por anclaje a ellos de los filamentos flagelares, se dedujo que el motor flagelar funciona como una mquina rotacional reversible , o sea, tiene dos sentidos: el de las agujas del reloj (AR) y el contrario (CAR). Veamos a continuacin las relaciones que se dan entre estos estados funcionales del motor y los fenmenos de rotacin en lnea y virajes bruscos. La natacin en lnea (carrera) se debe a la rotacin continua, durante un periodo de unos segundos, del motor, en sentido CAR. En las bacterias peritricas, las fuerzas hidrodinmicas y mecnicas hacen que los filamentos de los distintos flagelos se enrollen formando un haz o penacho paralelo al eje longitudinal de la clula. En este penacho, cada flagelo gira independientemente. El giro de los diversos filamentos helicoidales del penacho, empuja a la clula, originando la natacin en linea recta, con una velocidad de unos 25 mm/seg. Cuando el motor gira en sentido inverso, o sea AR, la nueva carga torsional que hace que el flagelo cambie de conformacin. Mientras est cambiando esa conformacin, cada filamento tira independientemente de un lado de la clula, lo que hace que esta pegue una voltereta que la reorienta de modo aleatorio.
1.5.2.2 COMPONENTES DEL MOTOR Y DEL CONMUTADOR
Como ya dijimos, parece que la empalizada de protenas integrales Mot A y Mot B forman parte del estator del motor. Esta empalizada rodea al doble anillo MS, y probablemente sobre esta base fija gira el rotor (FliG) situado bajo el doble anillo MS. Por debajo de ste, el anillo C, con sus tres tipos de protenas (FliG, M y N) acta como conmutador del sentido de giro. El giro se transmite solidariamente al cilindro central, de l al codo, y de ah al filamento helicoidal. Si no existiera sistema de conmutacin del sentido de giro, el motor girara siempre en sentido antihorario o sea, el sentido intrnseco (por defecto) de rotacin del motor flagelar es el CAR. Pero el motor recibe la influencia del sistema conmutador del anillo C, que de vez en cuando invierte el sentido de giro (AR). Como veremos luego, a su vez el sistema conmutador recibe informacin sensorial lo que se supondr que se alteraren las proporciones de tiempo en que el motor gira en un sentido o en otro.
1.5.2.3 ASPECTOS ENERGTICOS
En condiciones normales con disponibilidad de nutrientes energticos en el medio ambiente de la bacteria, la forma de energa que alimenta el motor flagelar es la fuerza protn motriz (f.p.m.), es decir, el potencial electroqumico de protones (y en las bacterias marinas y alcalfilas, la fuerza motriz de los iones Na+). La hiptesis actual sobre la manera en que se acopla el flujo de protones al motor con la rotacin dice lo siguiente: cuando los protones cruzan la membrana citoplsmica, se unen a un determinado asprtico de la protena MotB, lo cual le provoca un cambio conformacional. Este cambio conformacional del estator hace que el motor realice un paso de rotacin (una fraccin de un giro). Luego, ese protn sale de la protena MotB y entra al citoplasma, con lo que se regenera la configuracin original del estator. Para que el motor haga un giro completo, se necesitan unos 1000 protones. A su vez, el motor gira a la vertiginosa velocidad de 1000 revoluciones por minuto. De todas formas, la velocidad de rotacin es variable, y depende de la intensidad del gradiente de protones. De ese modo, la bacteria nada a altas velocidades relativas, de hasta 100 mm/seg., (si un coche corriera a la misma velocidad relativarompera la barrera del sonido!).
converted by Web2PDFConvert.com
�1.5.3 LAS TAXIAS
1.5.3.1 DEFINICIONES
En ausencia de un gradiente de estmulo, el movimiento de cada clula es a base de perodos de 2-4 segs de natacin separados por virajes. El movimiento en un gradiente de estmulo se logra variando la frecuencia de virajes: si la concentracin de un atrayente aumenta, o la de un repelente disminuye, las clulas no viran tan frecuentemente como lo haran en un entorno uniforme. Por lo tanto, el resultado es que nadan en la direccin favorable ms tiempo, y este sesgo respecto de la natacin aleatoria hace que exista un movimiento neto en relacin con el gradiente. Este mecanismo no es una taxia en sentido estricto (se le puede llama clinocinesis, aunque este trmino apenas se emplea); es un 50% menos efectivo que una taxia autntica, pero probablemente requiere mucha menos inversin en maquinaria sensorial y motora.
1.5.3.2 TIPOS DE TAXIAS
Se distinguen principalmente aerotaxia, fototaxia y quimiotaxia. 1) aerotaxia: respuesta de migracin ante un gradiente de oxgeno molecular. Bacterias anaerobias aerotaxia negativa. Bacterias microaerfilas atradas a tensiones ptimas de O2 (menores que la atmosfrica). Todas las bacterias aerobias y anaerobias facultativas aerotaxia positiva. La aerotaxia positiva, al menos en enterobacterias, y en bacterias purpreas en crecimiento heterotrfico, tiene un mecanismo diferente del mecanismo txico hacia otros atrayentes qumicos: no existe en realidad un receptor especfico del oxgeno. La seal estimulatoria consiste en la utilizacin del oxgeno como aceptor final de electrones en las cadenas transportadoras respiratorias. Esto provoca una alteracin de la f.p.m., que de alguna manera provoca un cambio que aumenta la probabilidad de giro del rotor en sentido CAR. 2) Las fototaxias de las bacterias fotosintticas anxicas dependen de un mecanismo similar: detectan un gradiente de intensidad de luz, no mediante un receptor especial, sino por medio del transporte de ee- fotosinttico, que a su vez provoca un cambio en el gradiente electroqumico de H+. Este cambio afecta al motor flagelar. 3) Las quimiotaxias, especialmente las de Enterobacterias, son las taxias mejor estudiadas. Las abordaremos a continuacin con cierto detalle.
1.5.3.3 ESTUDIODE LA QUIMIOTAXIA
Cuando se coloca a una bacteria en un gradiente de estmulo qumico se observa a lo largo del tiempo una respuesta con 3 fases distintas: fase de latencia (que dura unos 0.2 seg.), en la que el patrn de rotacin no se modifica. rpida excitacin (medida aqu como la probabilidad de encontrar al rotor girando en sentido CAR). fase de adaptacin lenta, hasta que se restablece el patrn inicial. El comportamiento de quimiotaxia se pone en marcha cuando un estmulo qumico determinado (un quimioefector) se une en la superficie bacteriana a un receptor especfico, lo que a su vez desencadena un proceso de transduccin intracelular de esta seal, que finalmente llega al complejo conmutador del corpsculo basal flagelar, lo que cambiar las proporciones iniciales de giro en sentido CAR y AR. Si el quimioefector produce una taxia positiva, se denomina quimioatrayente, mientras que si desencadena una taxia negativa se denomina quimiorrepelente. El sistema sensorial de la bacteria, ante un gradiente espacial de atrayente o repelente, origina una migracin neta (acercamiento o alejamiento, respectivamente) haciendo que la duracin de una carrera en la direccin favorable sea mayor, y para ello influye sobre el conmutador flagelar binario que determina el sentido de rotacin. La bacteria capta ese gradiente espacial, detectndolo de hecho como si fuera un gradiente temporal autogenerado por ella misma mientras va movindose. Como veremos, la bacteria compara, mediante el mismo receptor de membrana que capt el estmulo, la concentracin actual de la sustancia con la que tena en los segundos anteriores. Adems, la bacteria vuelve al patrn aleatorio de movimiento tras varios segundos o minutos del contacto inicial con el gradiente: existe un mecanismo de adaptacin al estmulo que, como veremos, implica una modificacin covalente de los receptores. Estos son los aspectos que vamos a pasar a considerar a continuacin.
1.5.3.3.1 ELEMENTOS DE RECEPCIN, TRANSDUCCIN DE SEAL y DE ADAPTACIN
En enterobacterias se ha estudiado bien la quimiotaxis dependiente de un tipo de protenas sensoras de estmulos qumicos denominadas MCP, acrnimo ingls de protenas quimiotcticas aceptoras de metilo, o simplemente transductores. En Escherichia coli se han identificado cinco MCP, y cada una responde a un conjunto determinado de quimiatrayentes y/o quimiorrepelentes. Por ejemplo, la MCP llamada Tar detecta los atrayentes asprtico y maltosa y los repelentes cobalto y nquel. Todas las MCP son protenas integrales de membrana citoplsmica, con un dominio periplsmico preparado para unirse a los
converted by Web2PDFConvert.com
�quimioefectores y un dominio citoplsmico dotado a su vez de dos zonas funcionales: una de ellas es la regin transductora que genera la seal intracelular que va a llegar al motor flagelar, y la otra es la regin metilable, con varios glutmicos que pueden aceptar
radicales metilo (-CH3). Los transductores MCP transmiten informacin al flagelo por medio de una cascada de transduccin intracelular de la seal, en la que estn implicadas seis protenas: CheA, CheW, CheY , CheZ, CheR y CheB.
CheA: Es una protenquinasa que se autofosforila en una His concreta cuando el MPC se une a un quimioefector. Es el regulador central del sistema quimiotctico, ya que en su forma fosforilada (CheA-P) fosforila a CheY y a CheB. CheW: es necesaria para el acoplamiento entre CheA y el dominio citoplsmico del MCP. CheY: la protena CheY es fosforilada en un determinado asprtico por la CheA-P, y en su forma CheY-P interacciona con el conmutador del anillo C del flagelo, lo cual incrementa la probabilidad de una inversin del giro desde el CAR al AR, con lo que aumenta la probabilidad de virajes. CheZ: contrarresta la seal de viraje al facilitar la desfosforilacin de CheY-P en CheY. CheR: es una metil-transferasa que cataliza la transferencia de grupos metilo desde la S-adenosil-metionina (SAM) hasta los glutmicos del dominio citoplsmico del MCP. CheB: cuando esta protena es fosforilada por la CheA-P, se convierte en una metilasa (CheB-P) que retira los metilos previamente unidos a los glutmicos del MCP.
Como veremos, la memoria celular para que la bacteria detecte gradientes de concentracin en funcin del tiempo es el resultado de la metilacin de las MCP por la CheR, y de su desmetilacin por CheB-P.
1.5.3.3.2 EL CICLO DE EXCITACIN-ADAPTACIN
1. En un ambiente neutro (ausencia de estmulo), la MCP tiene un nivel basal de metilacin (una media de un solo glutmico metilado en su dominio citoplsmico). En esta situacin, la CheA tiene un nivel basal de fosforilacin, que sirve para fosforilar a CheY y a CheB. El motor flagelar presenta un patrn de giro de unos cuantos segundos en sentido CAR ( natacin en lnea recta), y breves perodos de sentido AR ( virajes), que es la base del movimiento aleatorio de la bacteria. Ahora veremos cmo este flujo basal de informacin hacia el flagelo y de metilacin del MCP se altera con una sustancia atrayente. 2. Cuando aadimos el atrayente, ste se une al dominio periplsmico del MCP, lo que provoca un cambio conformacional que se transmite hasta el dominio citoplsmico, de modo que se produce una modificacin de la regin efectora de este dominio que transmite la seal hacia el motor flagelar. El tiempo que tarda en llegar al motor explica el periodo de latencia. Durante esta fase el nivel de metilacin no se altera, pero el cambio conformacional deja activados a los glutmicos metilables.
3. Transduccin intracelular de la seal: el cambio conformacional del dominio citoplsmico tiene el efecto de inhibir la activacin de la CheA, de modo que desciende el nivel basal de su autofosforilacin, lo que se traduce en que se fosforilan menos molculas de CheY y de CheB. Al haber menos CheY-P, llegan menos seales al conmutador flagelar de que cambie a sentido igual al de las agujas del reloj. Por lo tanto, se prolongan los perodos de natacin en lnea recta (y es ms probable que la bacteria se acerque al
estmulo qumico). 4. Mientras tanto, ha estado actuando la metiltransferasa (CheR), que ha ido aadiendo metilos a los glutmicos del dominio citoplsmico de la MCP. Si pasa un cierto tiempo y el dominio periplsmico sigue ocupado por el quimioatrayente, se alcanza un gran nivel de metilacin en ese dominio citoplsmico. Esto hace que el dominio efector citoplsmico vuelva a una configuracin nula, o sea, deja de emitirse seal excitadora. A ello colabora igualmente que el nivel de metilesterasa (la protena CheB-P, es decir la forma fosforilada) sea bajo. Esta es la explicacin molecular de por qu ocurre al cabo de unos segundos la adaptacin lenta al estmulo. Como la metilacin es relativamente lenta, esto significa que si en un determinado momento la concentracin actual de quimioefector (detectada por el grado de ocupacin del dominio periplsmico) es similar a la concentracin unos segundos antes (manifestada por el nivel de metilacin del dominio citoplsmico), la bacteria sabe que lleva ya un cierto tiempo acercndose al estmulo. Si la metilacin se ha estabilizado a un nivel alto, se produce un cambio conformacional por el que el MCP deja de emitir seal (estado nulo), y la bacteria se ha adaptado al estmulo.
Como ejercicio, veamos qu pasara si ponemos un repelente: la unin del repelente al MCP provoca un cambio conformacional que hace que el dominio citoplsmico interaccione ahora con el complejo CheWCheA de modo que se aumenta la tasa de autofosforilacin de CheA. Ahora esta CheA-P fosforila tanto a CheY como a CheB. La CheY-P difunde a la base del flagelo e interacciona con el conmutador (anillo C), y "da la orden" de que se cambie ms a menudo a giro en sentido de las agujas del reloj (AR), lo que hace que la bacteria vire caticamente ms a menudo. Con ello aumentan sus probabilidades de que encuentre una direccin de natacin ms favorable (en sentido opuesto al gradiente), en cuyo caso tendramos un patrn similar a cuando se une un atrayente. Mientras tanto, la CheR ha encontrado ms difcil acceder a los glutmicos, y el mayor nivel de la metilesterasa (CheB-P) hace que se eliminen metilos.
converted by Web2PDFConvert.com
�Esquema del funcionamiento del sistema de transduccin de la seal de un quimioatrayente (lee el texto para una explicacin completa)
2 FLAGELOS PERIPLSMICOS
Son un tipo de flagelos que presenta exclusivamente el grupo de las Espiroquetas. Estas bacterias Gram-negativas son extremadamente finas y de forma helicoidal. Estn compuestas de:
cilindro protoplasmtico, formado por el protoplasto rodeado de la capa de peptidoglucano. El sculo de murena de este PG tiene forma helicoidal, y es responsable de la tpica morfologa de estas bacterias; membrana externa; entre el cilindro protoplasmtico y la membrana externa se encuentran los peculiares flagelos, insertados subpolarmente y enrollados alrededor del cilindro. Estos flagelos se denominan flagelos periplsmicos (= endoflagelos = fibrillas axiales). Estructura: Cada flagelo, en s mismo, es similar al tipo de flagelo clsico ya estudiado:
corpsculo basal, con dos pares de anillos (excepto en Leptospira, con slo un par); codo filamento, a base de subunidades de flagelina. Ahora bien, lo caracterstico es la disposicin de los flagelos que salen de cerca de cada extremo, en relacin con el cuerpo celular:
Esquema de los flagelos periplsmicos de las espiroquetas
En la mayora de las especies, cada flagelo se extiende a lo largo del eje bacteriano, paralelo a la superficie del cilindro protoplasmtico, hasta alcanzar los 2/3 de la longitud total; esto se traduce en que los flagelos que salen de cada extremo se solapan en la zona central (la excepcin la tenemos en el gn. Leptospira, en que no se solapan). Las distintas fibrillas provenientes de cada extremo discurren paralelas y cercanas. El conjunto de estas fibrillas se manifiesta como filamento axial, recubierto por membrana externa. Obsrvese en el esquema el corte transversal de Cristispira, con sus numerosas fibrillas (=flagelos) axiales, que conjuntamente determinan un filamento axial prominente (cresta), envuelto, por supuesto, en membrana externa.
Papel de los endoflagelos en la movilidad de las espiroquetas
converted by Web2PDFConvert.com
�Los flagelos de estas bacterias, paralelos al eje longitudinal de la clula, estn anclados al cilindro protoplasmtico , que es rgido (mientras que la membrana externa es flexible). Al girar los flagelos de los dos extremos en el mismo sentido, obligan a girar al cilindro rgido en un sentido, y a la membrana externa en sentidos contrarios. El efecto es que el cilindro protoplasmtico gira en torno del filamento axial formado por los flagelos periplsmicos. Esta es la base de los distintos tipos de movimientos que podemos observar en estas bacterias: En medios lquidos se mueven por avance muy rpido a modo de torniquete (el cuerpo bacteriano se comporta como un sacacorchos) se pueden ver tambin contorsiones, latigazos, etc. Sobre la superficie de medios slidos: por rodamiento de la hlice. Esto se debe a que el filamento axial confiere movimiento de rotacin a la membrana externa, lo que se traduce en que la bacteria pueda rodar. (Tome el alumno un muelle, depostelo sobre una mesa y dle un empujn). Flexiones. Se provocan ondas propagables del cilindro. La bacteria puede avanzar a modo de las larvas de las mariposas gemetras Todos estos tipos de movimiento son adaptaciones evolutivamente conseguidas que permiten el rpido avance en medios de alta densidad (fangos espesos, mucosas de los animales, etc), medios donde los flagelos tpicos ya no pueden servir adecuadamente. La evolucin ha hecho que las espiroquetas se adapten, por su peculiar estructura y la de sus flagelos, a medios muy viscosos: de hecho, se mueven con mayor rapidez a 300-500 cP que a 10-50 cP. Presentan, adems taxias positivas hacia esos medios viscosos.
3 FIMBRIAS O PELOS (= PILI)
Son apndices filamentosos rectos y rgidos, ms cortos y ms finos (3-10 nm de dimetro) que los flagelos, y que aparecen en muchas bacterias (sobre todo Gram-negativas). La mayora estn compuestos por un solo tipo de protena (la pilina), de unos 17-25 kDa, cuyas subunidades se disponen en una matriz helicoidal que deja un pequeo hueco central. Estn implantados a nivel de membrana citoplsmica. Nmero variable: desde 1 a varios cientos o miles por clula. Disposicin: alrededor de todo el permetro celular, y a veces, de insercin polar. Aislamiento: por simple agitacin mecnica de las clulas, seguido de ultracentrifugacin. Composicin: ensamblaje de subunidades de pilina, protena globular muy hidrfoba. Ensamblaje: insercin de subunidades de pilina en la base del pelo en crecimiento, a partir de pre-pilina, que se procesa por escisin del correspondiente pptido-lder a su paso por la membrana citoplsmica. Existen dos tipos principales de pili (pilus, en singular): fimbrias adhesivas pelos sexuales
3.1 FIMBRIAS ADHESIVAS
Son pelos de 4 a 7 nm de dimetro (segn especies), repartidas por toda la superficie y que funcionan como adhesinas, es decir como estructuras para la adhesin a sustratos vivos o inertes. Condicionan varias propiedades biolgicas, derivadas de sus propiedades adhesivas: microcolonias y velos (los velos son pelculas formadas por acmulos de bacterias en medios estticos -en reposo-). adhesin a superficies inertes adhesin superficies vivas. En el caso de bacterias patgenas, esta capacidad tiene que ver con su virulencia, invasividad del tejido. Ejemplos de funcin como adhesinas: en la formacin de la placa dental, por coagregacin de individuos de distintas especies sobre el diente; factores de colonizacin de tejidos, por ejemplo en el gonococo (Neisseria gonorrhoeae) y en las cepas uropatognicas de
Escherichia coli.
La funcin de adhesina no reside en la pilina que constituye la inmensa mayora de la fimbria, sino en una protena especial de la punta del pelo. La mayora de estas protenas de la punta pertenecen a la clase de las llamadas lectinas, es decir, protenas o glucoprotenas capaces de unirse con gran afinidad a cadenas laterales de polisacridos presentes en la membrana citoplsmica de las clulas del hospedador a las que se adhieren.
Aspectos genticos :
Los genes codificadores de las protenas de los pelos adhesivos son de localizacin cromosmica. En muchas bacterias patgenas se da un fenmeno de variacin de fase: se trata de cambios rpidos y reversibles por los que clulas piliadas (Fim+) pueden convertirse en no piliadas (Fim--), y viceversa. El significado adaptativo es que los individuos Fim+ son los ms capaces de iniciar la colonizacin del animal hospedador, pero son ms sensibles a la fagocitosis, mientras que una vez que han colonizado el epitelio, el cambio a Fim-- permite que los individuos resistan mejor la fagocitosis. Pero adems, existe otro interesante mecanismo adaptativo: las clulas Fim+ de algunas especies experimentan fenmenos de variacin antignica, es decir, por una serie de mecanismos genticos, cambian la especificidad antignica de su pilina, lo que supone una estrategia de evitacin contra el sistema inmune del hospedador (un caso ms de esa carrera de armamentos evolutiva
converted by Web2PDFConvert.com
�que se libra entre microorganismos y organismos superiores). Algunas pilinas (por ejemplo, en los gneros Moraxella y Neisseria) sirven tambin como parte del aparato necesario para la transformacin gentica por ADN exgeno.
3.2 PELOS SEXUALES DE BACTERIAS GRAM-NEGATIVAS
Son ms largos y ms gruesos (unos 10 nm de dimetro) que las fimbrias adhesivas. Aparecen en menor nmero (de 1 a 10 por clula), y su funcin es la de permitir los contactos iniciales en la conjugacin , como rgano de reconocimiento entre la bacteria donadora, dotada del pelo sexual, y la receptora, carente de l. Sus genes son de localizacin plasmdica. Hay dos clases principales de pelos sexuales: los de de tipo F y los de tipo I, cada uno con un tipo de protena distinta (genricamente conocida como pilina sexual). Son usados como receptores especficos por parte de algunos fagos. Hablaremos de los pelos sexuales cuando abordemos el captulo de Conjugacin bacteriana.
4 PROSTECAS
Son prolongaciones semirrgidas vivas , propias de ciertas bacterias, con un dimetro menor que el cuerpo celular. Es decir, son apndices del cuerpo celular rodeados por membrana y pared celulares.
Funciones:
1) En algunas bacterias prostecadas funcionan en la reproduccin (prostecas reproductivas o hifas ). Ejemplos: Hyphomicrobium,
Hyphomonas.
2) En Caulobacter acta como apndice para unin a sustratos inertes o para la formacin de rosetas de varios individuos, merced al botn de anclaje situado en el extremo 3) En general, suponen un modo de aumentar la relacin superficie/volumen , lo cual redunda en: a) mayor capacidad de flotabilidad para ciertas bacterias planctnicas; b) mayor superficie para la captacin de nutrientes en ambientes oligotrficos. Ejemplos: Ancalomicrobium, Prosthecomicrobium, Stella, etc.
5 TALLOS O PEDNCULOS
Son estructuras filamentosas no vivas, terminadas en botones de anclaje (discos adhesivos), producidas por secrecin continua de materiales polisacardicos en una zona concreta de la superficie bacteriana.
Funcin: Permite la unin de ciertas bacterias de hbitats acuticos a sustratos slidos, vivos o no. Ejemplos: Gallionella: es una bacteria con forma de media luna, de cuyo lado cncavo surgen de 3 a 40 filamentos helicoidales, terminados en
botones de anclaje. Planctomyces: es una bacteria con forma de pera, con flagelo subpolar, que pasa parte de su vida anclada a sustratos por medio de un tallo constituido por numerosas fibras rectas.
ENLACES
Para empezar, un artculo de una enciclopedia on-line que describe brevemente los flagelos procariotas y eucariotas. Interesantes vdeos sobre la movilidad por flagelos (Universidad de Harvard) Para no perderse: El proyecto "nanomquina" nos asombra con unos espectaculares videos en 3-D sobre el flagelo. El que trata sobre el ensamblaje es para quitarse el sombrero El profesor Howard Berg escribe una estupenda pgina sobre el flagelo y la quimiotaxis, con figuras muy instructivas El profesor Macnab, uno de los mximos especialistas en flagelos bacterianos nos deleita con una revisin centrada en el motor flagelar Una serie de imgenes tridimensionales sobre el ensamblaje del flagelo Una pgina sobre quimiotaxis mantenida por la Universidad de Bristol Una pgina sobre el curioso movimiento por sacudidas, debido a pelos de tipo IV (con videos) Una pgina sencilla sobre los distintos tipos de fimbrias y pelos (Universidad de Newcastle)
converted by Web2PDFConvert.com
�[ Introduccin e Historia ] [ Rasgos generales procariotas ] [ Tamao y forma ] [ Estructuras superficiales ] [ Paredes procariotas ] [ Sntesis peptidoglucano ] [ Membrana y transporte ] [ Citoplasma y su contenido ] [ Apndices filamentosos procariotas ] [ Diferenciaciones celulares ] [ Captacin de energa ] [ Nutricin microbiana ] [ Ciclo celular y crecimiento ] [ Agentes fsicos ] [ Agentes qumicos ] [ Regulacin gnica ] [ Mutaciones en procariotas ] [ Recombinacin. Transformacin ] [ Conjugacin ] [ Transduccin ]
Otras partes de esta web:
converted by Web2PDFConvert.com